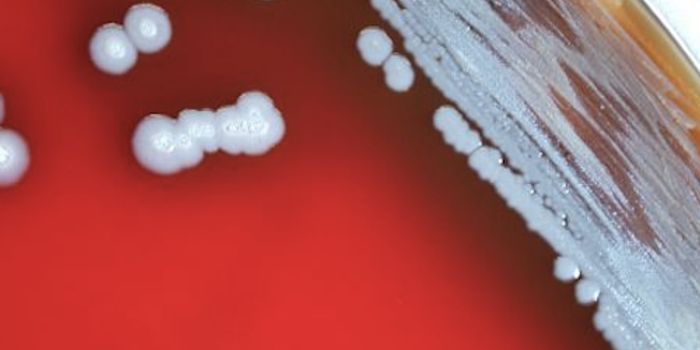
How A Virus Impacts a Bacterium that Infects People

Predictive modelling
Predictive modelling is a statistical technique used to predict future events or health outcomes. Predictive modelling involves extensive analysis of current and historical data to estimate future trends.
-
NOV 05, 2018NeuroscienceUnderstanding the brain cells involved in decoding and encoding naviagtional information.Written By: Aswini KannegantiOCT 31, 2018VideosWhat's your record for how many times you can skip a stone? Turns out the current world record for Most Consecutive ...Written By: Kathryn DeMuth SullivanOCT 26, 2018Chemistry & PhysicsEarly October, a 96-year old New Yorker of East European descendence passed away in a small northwest town. To those who ...Written By: Daniel DuanOCT 15, 2018Plants & AnimalsMany shelled animals, including the humble sea snail, call the ocean their home. But as increased carbon dioxide levels ...Written By: Anthony BouchardOCT 15, 2018Plants & AnimalsAs climate change rears its ugly head, Winters are getting shorter and the Spring season is kicking off earlier in the y ...Written By: Anthony BouchardOCT 09, 2018Genetics & GenomicsThis tool might be used in the future to forecast many different traits.Written By: Carmen LeitchOCT 06, 2018Genetics & GenomicsIn a first, researchers have found a genetic mutation that has a sex-specific effect on pancreatic cancer risk.Written By: Carmen LeitchSEP 27, 2018NeuroscienceNeuroscientists all over the globe are actively looking for more effective treatments for Alzheimer's disease, but i ...Written By: Brenda Kelley KimSEP 25, 2018Plants & AnimalsMost people would agree that plastic pollution is a problem that we can no longer afford to ignore; especially in that o ...Written By: Anthony BouchardSEP 20, 2018MicrobiologyYou may have never heard of melioidosis, also known as Whitmore's disease, but it is a scary infection in many parts of ...Written By: Carmen LeitchSEP 18, 2018Drug Discovery & DevelopmentFighting disease using the immune system is the body’s most prized possession and it does so by utilizing immunoth ...Written By: Nouran AminSEP 18, 2018Earth & The EnvironmentAfter the last wildfire season, it’s an understatement to say that we need to get better at developing technology ...Written By: Kathryn DeMuth SullivanSEP 18, 2018Cell & Molecular BiologyInstead of fluorescent labeling, scientists found a way to use computers to identify cellular structures.Written By: Carmen LeitchSEP 16, 2018TechnologyAccording to a study published in Nature Biomedical Engineering, researchers at Johns Hopkins University have performed ...Written By: Nouran AminSEP 15, 2018Genetics & GenomicsThis tool might be extrapolated for many other disorders, and may free patients from repeated doctor visits.Written By: Carmen LeitchSEP 14, 2018Earth & The EnvironmentA new study published in the Proceedings of the National Academy of Sciences takes a fresh look on just how much clouds ...Written By: Kathryn DeMuth SullivanSEP 11, 2018Earth & The EnvironmentThe 2018 report released by the United Nations' on the State of Food Security and Nutrition in the World on Tuesday ...Written By: Kathryn DeMuth SullivanSEP 09, 2018Earth & The EnvironmentA new study published in Science suggests that the installing large-scale clean energies in the Sahara Desert could ...Written By: Kathryn DeMuth SullivanSEP 05, 2018Plants & AnimalsSetting out bird feeders stocked with fresh seeds is a common practice among bird lovers and nature appreciators. But wo ...Written By: Anthony BouchardSEP 05, 2018Earth & The EnvironmentA warming climate will ultimately favor some species over others. One such species is a parasite called the liver fluke, ...Written By: Kathryn DeMuth SullivanSEP 04, 2018Space & AstronomyAstronomers still have many questions about the universe. One of those being: what is the universe’s shape? It may ...Written By: Anthony BouchardAUG 27, 2018Space & AstronomyWhile exploring the depths of the universe, astronomers from Durham University’s Institute for Computational Cosmo ...Written By: Anthony BouchardAUG 22, 2018Clinical & Molecular DXA research study led by Beth Israel Deaconess Medical Center has discovered a tumor biomarker that could be used to dete ...Written By: Nouran AminAUG 21, 2018Cell & Molecular BiologyMiniature, simplified versions of human brains were just improved with the addition of an important cell type.Written By: Carmen Leitch
NOV 05, 2018
Neuroscience
Understanding the brain cells involved in decoding and encoding naviagtional information.
Written By:
Aswini Kanneganti
OCT 31, 2018
Videos
What's your record for how many times you can skip a stone? Turns out the current world record for Most Consecutive
...
Written By:
Kathryn DeMuth Sullivan
OCT 26, 2018
Chemistry & Physics
Early October, a 96-year old New Yorker of East European descendence passed away in a small northwest town. To those who
...
Written By:
Daniel Duan
OCT 15, 2018
Plants & Animals
Many shelled animals, including the humble sea snail, call the ocean their home. But as increased carbon dioxide levels
...
Written By:
Anthony Bouchard
OCT 15, 2018
Plants & Animals
As climate change rears its ugly head, Winters are getting shorter and the Spring season is kicking off earlier in the y
...
Written By:
Anthony Bouchard
OCT 09, 2018
Genetics & Genomics
This tool might be used in the future to forecast many different traits.
Written By:
Carmen Leitch
OCT 06, 2018
Genetics & Genomics
In a first, researchers have found a genetic mutation that has a sex-specific effect on pancreatic cancer risk.
Written By:
Carmen Leitch
SEP 27, 2018
Neuroscience
Neuroscientists all over the globe are actively looking for more effective treatments for Alzheimer's disease, but i
...
Written By:
Brenda Kelley Kim
SEP 25, 2018
Plants & Animals
Most people would agree that plastic pollution is a problem that we can no longer afford to ignore; especially in that o
...
Written By:
Anthony Bouchard
SEP 20, 2018
Microbiology
You may have never heard of melioidosis, also known as Whitmore's disease, but it is a scary infection in many parts of
...
Written By:
Carmen Leitch
SEP 18, 2018
Drug Discovery & Development
Fighting disease using the immune system is the body’s most prized possession and it does so by utilizing immunoth
...
Written By:
Nouran Amin
SEP 18, 2018
Earth & The Environment
After the last wildfire season, it’s an understatement to say that we need to get better at developing technology
...
Written By:
Kathryn DeMuth Sullivan
SEP 18, 2018
Cell & Molecular Biology
Instead of fluorescent labeling, scientists found a way to use computers to identify cellular structures.
Written By:
Carmen Leitch
SEP 16, 2018
Technology
According to a study published in Nature Biomedical Engineering, researchers at Johns Hopkins University have performed
...
Written By:
Nouran Amin
SEP 15, 2018
Genetics & Genomics
This tool might be extrapolated for many other disorders, and may free patients from repeated doctor visits.
Written By:
Carmen Leitch
SEP 14, 2018
Earth & The Environment
A new study published in the Proceedings of the National Academy of Sciences takes a fresh look on just how much clouds
...
Written By:
Kathryn DeMuth Sullivan
SEP 11, 2018
Earth & The Environment
The 2018 report released by the United Nations' on the State of Food Security and Nutrition in the World on Tuesday
...
Written By:
Kathryn DeMuth Sullivan
SEP 09, 2018
Earth & The Environment
A new study published in Science suggests that the installing large-scale clean energies in the Sahara Desert could
...
Written By:
Kathryn DeMuth Sullivan
SEP 05, 2018
Plants & Animals
Setting out bird feeders stocked with fresh seeds is a common practice among bird lovers and nature appreciators. But wo
...
Written By:
Anthony Bouchard
SEP 05, 2018
Earth & The Environment
A warming climate will ultimately favor some species over others. One such species is a parasite called the liver fluke,
...
Written By:
Kathryn DeMuth Sullivan
SEP 04, 2018
Space & Astronomy
Astronomers still have many questions about the universe. One of those being: what is the universe’s shape? It may
...
Written By:
Anthony Bouchard
AUG 27, 2018
Space & Astronomy
While exploring the depths of the universe, astronomers from Durham University’s Institute for Computational Cosmo
...
Written By:
Anthony Bouchard
AUG 22, 2018
Clinical & Molecular DX
A research study led by Beth Israel Deaconess Medical Center has discovered a tumor biomarker that could be used to dete
...
Written By:
Nouran Amin
AUG 21, 2018
Cell & Molecular Biology
Miniature, simplified versions of human brains were just improved with the addition of an important cell type.
Written By:
Carmen Leitch